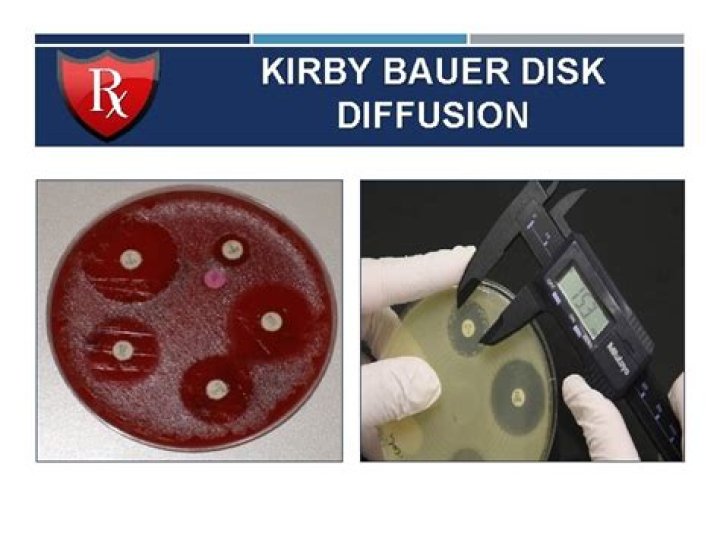
Cover

Are you Dr. Riccio?
Join over one million U.S. Physicians, Nurse Practitioners and PAs, already on Doximity.
- Connect with colleagues in the same hospital or clinic
You already have37 invites waiting! - Search all U.S. specialist profiles and refer a patient
- Read the latest clinical news and earn CME/CEU credits